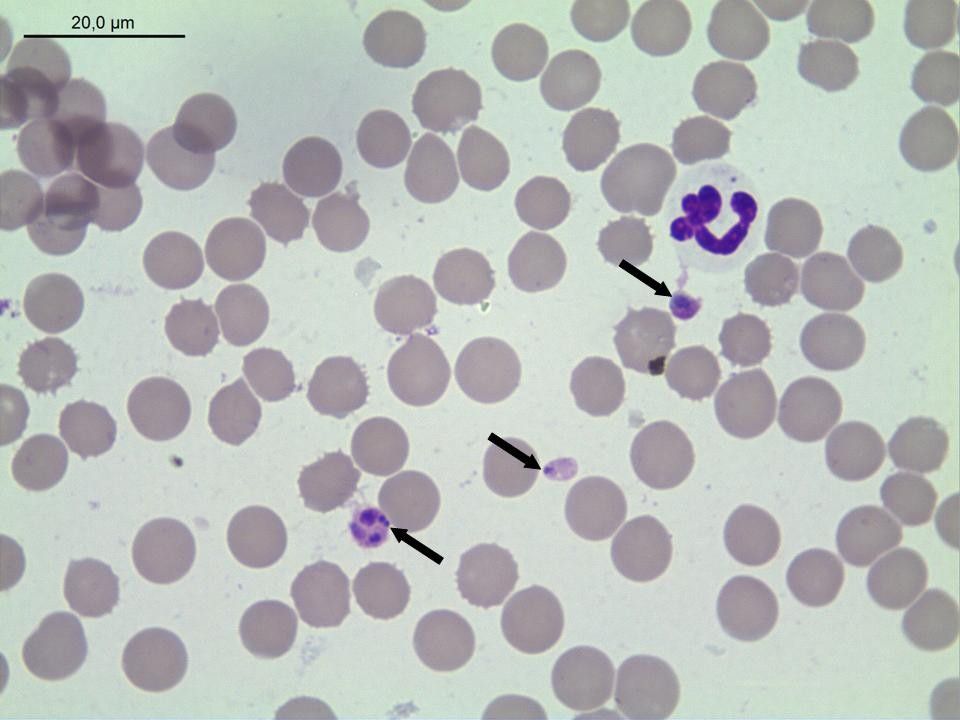

Ahora que empieza la época más cruda para nuestros perros y gatos, vamos a hablaros de las enfermedades que transmiten las garrapatas. Hay otros vectores, como mosquitos y flebotomos, pero nos centraremos en estos ácaros.
Las Garrapatas son, por detrás de los mosquitos, el vector más importante en la transmisión de enfermedades, tanto a los animales de compañía como al hombre. Además de producir efectos sobre la piel, anemias y debilidad debido a las pérdidas de sangre.
Hay muchos tipo de garrapatas según las zonas en las que se viva, y conviene conocer cuáles son y el tipo de enfermedades que pueden transmitir.
CLASIFICACIÓN DE LAS DISTINTAS ESPECIES
Las garrapatas, desde el punto de vista taxonómico se clasifican en dos grandes familias: Argasidae (garrapatas blandas) e Ixodidae (garrapatas duras).
En España son las garrapatas de la familia Ixodidae las que parasitan a nuestros perros y gatos siendo las especies más habituales. Rhipicephalus sanguineus, Dermatocentor reticulatus, Ixodes ricinus e Ixodes hexagonus. Siendo el R. sanguineus la más frecuente.

ENFERMEDADES TRANSMITIDAS AL PERRO
ERLICHIOSIS MONOCÍTICA CANINA
Su agente causal es una bacteria, la Erlichia canis y el vector principal es el Ripicephalus sanguineus.

Los signos clínicos más frecuentes que vamos a encontrar en el perro son:
- Apatía.
- Depresión.
- Anorexia
- Fiebre.
- Ganglios inflamados
- Pérdida de peso
- Palidez de mucosas
- Esplenomegalia (inflamación del bazo)
Signos hemorrágicos:
- Petequias (lesiones pequeñas de color rojo, formadas por extravasación de un número pequeño de eritrocitos cuando se daña un capilar)
- Equimosis (Extravasación de sangre)
- Epístaxis (hemorragia nasal)
Signos oculares:
- Uveítis ( es la inflamación de la capa media del ojo, situada entre la esclerótica por fuera y la retina por dentro, que afecta al iris, cuerpo ciliar, la pars plana y/o la coroides. A veces, por extensión, puede afectar también a la retina.
Signos respiratorios y signos neurológicos.
El diagnóstico se lleva a cabo mediante serología como inmunofluorescencia indirecta (IFI), por inmunofluorescencia ligada a enzimas (ELISA) y PCR (detección del ADN del agente infeccioso).
El Tratamiento de elección es la doxiciclina.
ANAPLASMOSIS CANINA
ANAPLASMOSIS GRANULOCÍTICA CANINA. Su agente causal es una bacteria, el Anaplasma phagocytophilum y el vector principal es el Ixodes ricinus.
La enfermedad cursa con fiebre, letargo, anorexia y esplenomegalia y es habitual el hallazgo de anemia, también puede cursar, en ocasiones, con signos neurológicos y ortopédicos.
ANAPLASMOSIS TROMBOCÍTICA CANINA. Su agente causal es una bacteria, el Anaplasma platys y el vector es el Ripicephalus sanguineus,
La bacteria infecta plaquetas y es menos patógena, aunque cursa con trombocitopenia y fiebre, que aparece y desaparece de forma cíclica cada una o dos semanas.
El diagnóstico se lleva a cabo mediante serología y PCR
El tratamiento de elección es la doxiciclina.
BABESIOSIS CANINA
La babesiosis está causada por protozoos del género Babesia, la especie más frecuente descrita en España es la Babesia canis y su vector principal es la garrapata Dermocentor reticulatus, también se han descrito infecciones por B. vogeli, B. gibsoni y B. micro-like.

De forma general, las babesias infectan a los eritrocitos (glóbulos rojos) y producen anemia hemolítica. El cuadro puede ser subclínico o, por el contrario, hiperagudo, agudo o crónico.
El diagnóstico se puede hacer mediante frotis directo de la sangre al microscopio, donde observaremos las babesias dentro de los glóbulos rojos, también en un análisis serológico tras dos semanas postinfección, e incluso por pruebas específicas de PCR para diagnosticar cuadros crónicos.
El tratamiento se realiza con dipropionato de imidocard en babesias grandes. Para las pequeñas se emplea atovacuona junto a azitromicina, aunque la eliminación de este parásito es complicada.
HEPATOZOONOSIS CANINA
Está causada por un protozoo, el Hepatozzon canis y transmitida por la garrapata Rhipicephalus sanguineus tras ingerir la garrapata y no por su picadura.

Se han descrito en perros de caza sobre todo y produce signos musculares debido a la migración de los protozoos al músculo esquelético.
El diagnóstico se puede realizar mediante frotis de sangre o en muestra de tejido. También hay desarrolladas pruebas serológicas y pruebas PCR.
Hay varios tratamientos que podemos utilizar, el diprionato de imidocard, el toltrazuril junto a emodepside y la clindamicina.
BORRELIOSIS (ENFERMEDAD DE LYME)
Esta enfermedad está causada por espiroquetas de la especie Borrelia burgdorferi y transmitida por la garrapata Ixodes ricinus en España.
Tiene una gran relevancia desde el punto de vista de la salud pública, ya que se transmite a las personas a través de la mordedura de la garrapata infectada.

Se aprecian cojeras intermitentes, fiebre y en algunas ocasiones glomerulopatías.
El diagnóstico se puede realizar a través de pruebas serológicas, siendo detectables los anticuerpos a partir de las tres a cinco semanas postinfección.
El tratamiento se basa en el empleo de doxiciclina, aunque también se puede usar amoxicilina, azitromicina y cefalosporinas.
RICKETTSIOSIS CANINA
Está producida por bacterias del género Rickettsia, la especie Rickettsia conorii transmitida por la garrapata Rhipicephalus sanguineus les produce fiebre intermitente.

En España se han descrito nuevas especies que pueden infectar al perro , pero todavía no se conoce su capacidad patogénica.
Tiene relevancia porque produce en el hombre la fiebre botonosa mediterránea si se produce la picadura de una garrapata infectada.
Existen pruebas serológicas para su diagnóstico, además de poder realizar un diagnóstico por PCR.
Se puede usar como tratamiento doxiciclina y azitromicina.
ENFERMEDADES TRASMITIDAS AL GATO
De forma general, el gato presenta una menor prevalencia de las enfermedades transmitidas por garrapatas, ello es debido a que salen menos fuera y a la frecuencia de acicalado, que hace que las garrapatas se desprendan enseguida, impidiendo así la transmisión eficaz de los agentes. También es posible que tengan una resistencia natural a estos patógenos y sus vectores. A pesar de todo, el gato también puede ser parasitado e infectado.
ERLICHIOSIS FELINA
En España se han encontrado ya casos de Erlichiosis en gatos y su agente vector en la garrapata Rhipicephalus sanguineus. Se ha detectado el agente patógeno Ehrlichia canis en muestras sanguíneas felinas, así como su ADN y anticuerpos para este agente.
El signo clínico detectado con mayor frecuencia es la fiebre, asociada en ocasiones a hiperproteinemia y trombocitopenia.
Se diagnostica a través de pruebas serológicas, por PCR o por detección del agente en el frotis sanguíneo.
El antibiótico de elección es la doxiciclina.
ANAPLASMOSIS FELINA
Al igual que en el perro los agentes causales son el Anaplasma phagocytophilum transmitido por el Ixodes ricinus y el Anaplasma platys transmitido posiblemente por el Rhipicephalus sanguineus.
Los signos clínicos que encontramos en los gatos infectados por esta bacteria son fiebre, letargo y anorexia.
La mejor técnica de diagnóstico es por PCR, debido a que un 30% de los gatos con signos clínicos de infección son seronegativos en la fase aguda.
El tratamiento de elección es la doxiciclina, observándose gran mejoría de los signos clínicos, aunque muchas veces no se consigue la eliminación total de la bacteria.
BABESIOSIS FELINA
Se han descrito casos de infección por Babesia canis y Babesia microti-like en gatos de España y Portugal. Sin embargo, existe poca información acerca de su patogenia e, incluso, acerca del vector implicado en su transmisión.
La técnica de elección para su diagnóstico es por PCR, ya que la serología no distingue la infección por babesias de otros piroplasmas.
El tratamiento de elección es la primaquina, mientras que la combinación de trimetropim y sulfadiazina se consideran menos eficaces.
HEPATOZOONOSIS FELINA
Se han descrito casos de hepatozoonosis felina por Hepatozzon felis, Hepatozzon canis y, recientemente, Hepatozzon silvestris en Europa.
La infección es subclínica y los signos pueden aparecer en gatos estresados, inmunocomprometidos o con alguna otra infección.
Se han encontrado recientemente ADN de Hepatozzon spp. en gatos de la zona centro de España, asociados a bajo hematocrito y aumento de creatinina.
El diagnóstico se puede realizar mediante la observación de muestras de tejido muscular o en frotis sanguíneo, pero la prueba de elección es la PCR a partir de muestras de sangre.
Se ha descrito el uso de doxiciclina en combinación con oxitetraciclina y primaquina.
MÉTODOS DE PREVENCIÓN Y CONTROL
Existen en el mercado una amplia variedad de productos acaricidas en distintos formatos y vías de administración. Estos productos están destinados a la prevención y el tratamiento de ectoparásitos a través del bloqueo de la neurotransmisión de la garrapata utilizando varios mecanismos.
- Piretrinas en perros (en gatos son muy tóxicas) – Modificando los canales de sodio.
- Fipronilo, moxidectina o selamectina – Actuando sobre los canales de cloro.
- Imidacloprida – Agonistas de los receptores nicotínicos.
- Triclorfón, diclorvos o propoxur – Como anticolinesterásicos.
- Amitraz -Agonistas dopaminérgicos.
- Recientemente han aparecido las isoxalinas (sarolaner, afoxolaner, y fluralaner) que producen una estimulación nerviosa en la garrapata.
La mayoría de los productos empleados incluyen, al menos, la combinación de dos de los grupos mencionados, con el objetivo de disminuir la toxicidad en perros y gatos y aumentar su efectividad.
Lo más importante es acudir a tu veterinario, que será el que te indique el mejor producto para tu perro o gato, ya que, como hemos visto, según la región hay que aplicar un medicamento u otro. Y sobre todo pensar que hay animales a los que los collares o pipetas les producen reacciones alérgicas, por lo que en esos casos habrá que utilizar medicamentos orales.
Lina Sáez de Antoni – colegiada 1.498 – Madrid





